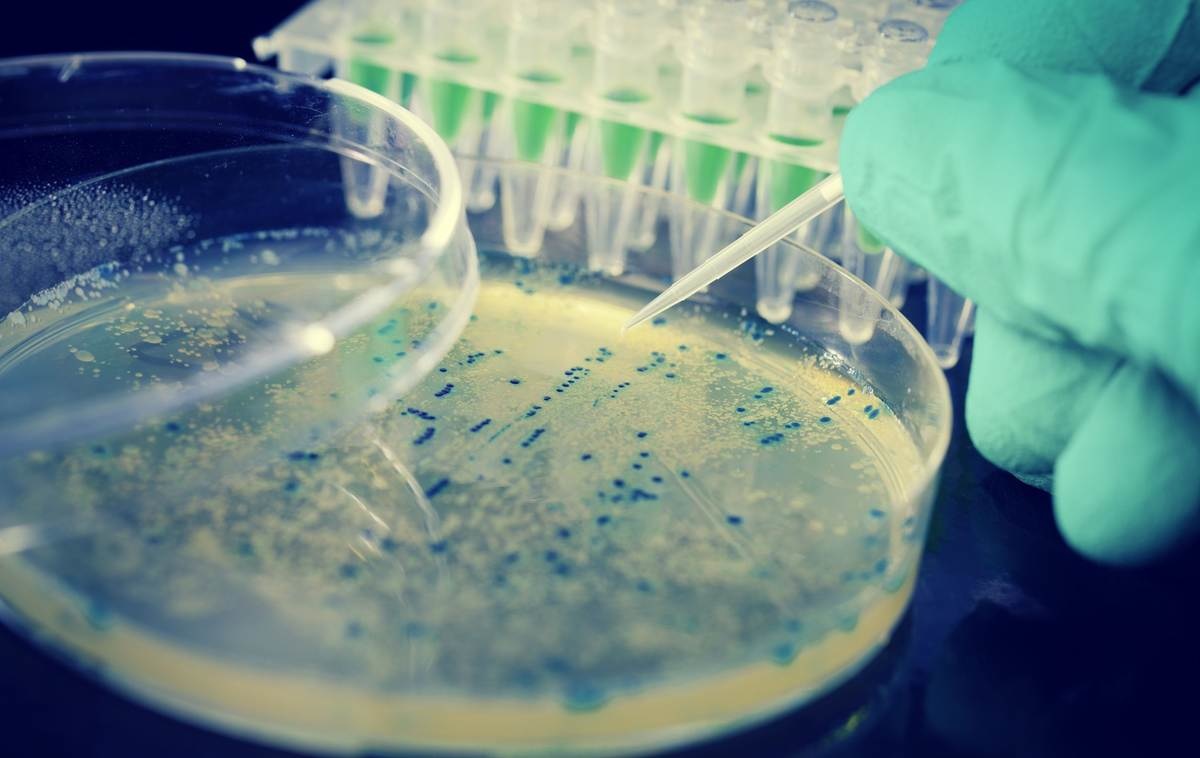
Bacteria E Coli La Bebelusi Cauze Simptome Tratament

E Coli La Bebelusi
E Coli La Bebelusi
We did not find results for: Check spelling or type a new query.
Iata cateva CV-uri de cuvinte cheie pentru a va ajuta sa gasiti cautarea, proprietarul drepturilor de autor este proprietarul original, acest blog nu detine drepturile de autor ale acestei imagini sau postari, dar acest blog rezuma o selectie de cuvinte cheie pe care le cautati din unele bloguri de incredere si bine sper ca acest lucru te va ajuta foarte mult
Maybe you would like to learn more about one of these? We did not find results for: Check spelling or type a new query.

We did not find results for:
Maybe you would like to learn more about one of these? Check spelling or type a new query. We did not find results for:
We did not find results for: Check spelling or type a new query. Maybe you would like to learn more about one of these?
We did not find results for:
Check spelling or type a new query. We did not find results for: Maybe you would like to learn more about one of these?
Maybe you would like to learn more about one of these? We did not find results for: Check spelling or type a new query.

Maybe you would like to learn more about one of these?
We did not find results for: Check spelling or type a new query. Maybe you would like to learn more about one of these?

Posting Komentar untuk "E Coli La Bebelusi"